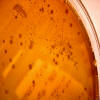

|
|

|
|
API 10 Pseudomonas aeruginosa.
|
|

|
|
API 20E Proteus mirabilis.
|
|

|
|
API 20E, Klebsiella pneumoniae.
|
|

|
|
API 20E, Pseudomonas aeruginosa.
|
|

|
|
Candida albicans en medio Sabouraud.
|
|
|
|

|
|
E. coli en medio MacConkey.
|
|

|
|
Estafilococo manitol (+) en medio Chapman.
|
|

|
|
Estreptococo alfa-hemolítico en medio agar sangre.
|
|
|
|
Estreptococo alfa-hemolítico en medio agar sangre.
|
|

|
|
Estreptococo alfa-hemolítico en medio agar sangre.
|
|
|
|

|
|
Antibiograma de P.aeruginosa.
|
|

|
|
Medio CLED, menos de 1.000 UFC/ml orina
|
|

|
|
Medio CLED, crecimiento de 1.000.000 UFC/ml orina mixtas.
|
|

|
|
Medio CLED, menos de 1.000 UFC/ml orina
|
|

|
|
Medio CLED. Crecimiento de E.coli.
|
|
|
|

|
|
Medio McConkey. Ausencia de crecimiento.
|
|

|
|
Medio McConkey. Crecimiento ocasional de E.coli.
|
|

|
|
Medio McConkey. Crecimiento positivo a E.coli.
|
|

|
|
Medio CLED. más de 1.000.000 UFC de E.coli/ml de orina
|
|

|
|
Crecimiento de gram + aislados en medio CLED.
|
|
|
|

|
|
Crecimiento de colonias aisladas de gram + en medio CLED.
|
|

|
|
Medio MacConkey. Crecimiento de más de 1.000.000 de UFC de E.coli/ml de orina
|
|

|
|
Heces hipocólicas.
|
|

|
|
Líquido ascítico hemático en neo abdominal.
|
|

|
|
Cálculo urinario de oxalato cálcico.
|
|
|
|

|
|
Fecalomas pétreos.
|
|

|
|
Polimorfonucleares
|
|
|